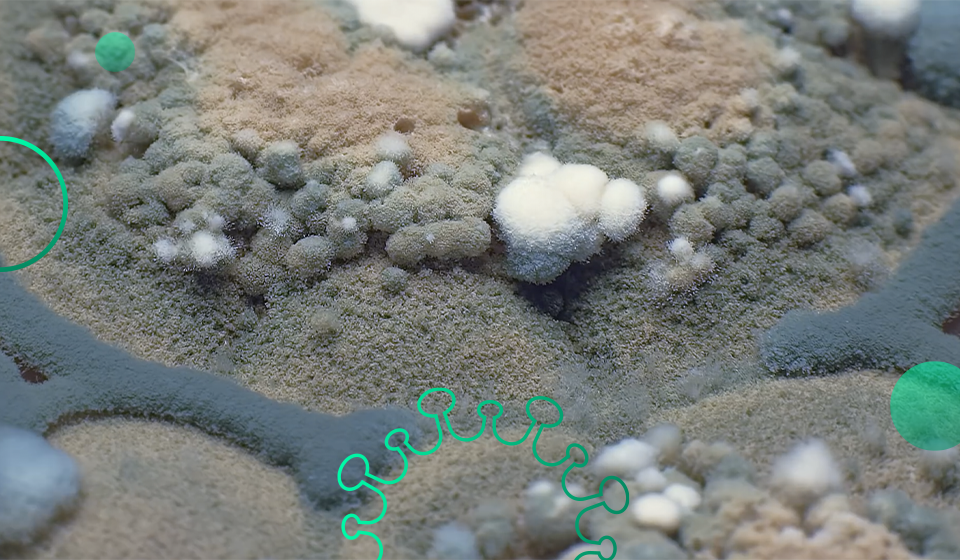

WHAT IS MOLD?
Mold or mould is a type of fungi that grows in multicellular structures called hyphae. These hyphae produce the mold spores that are found indoors and outdoors. Although mold spores are found everywhere, in order to grow, mold requires moisture. Therefore, mold can be particularly prevalent in refrigerators and shower rooms, after a water pipe leak, or in the aftermath of flooding. There are thousands of different species of mold; some are used to produce common things like medicine (namely penicillin) and foods. However, when mold grows in your home or business, it can be detrimental, causing property damage and health issues.
When mold starts to invade your home, dealing with the problem quickly and safely should be a priority. It can take less than 48 hours for mold to spread throughout your home, which may result in negative health effects to your family, as well as damage to your property. Goodbye Mold responds quickly to your call to assess your situation. Our team use advanced equipment and experience in mold mitigation to determine the water source of your mold problem, that´s the key.